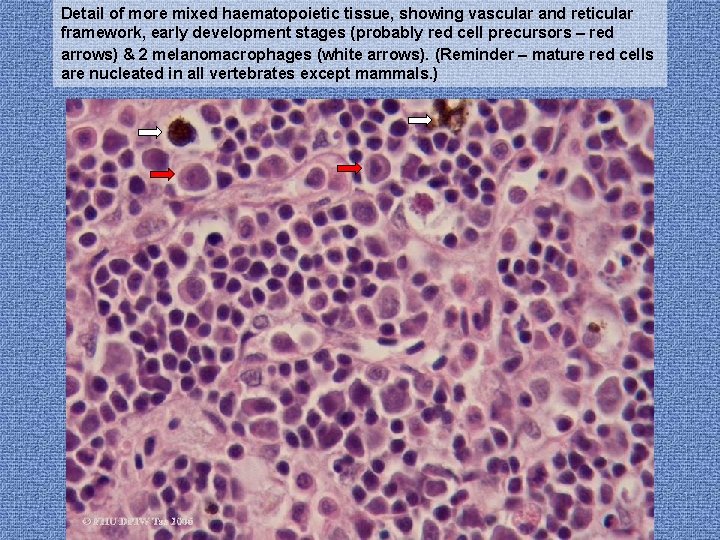
Detail of more mixed haematopoietic tissue, showing vascular and reticular framework, early development stages
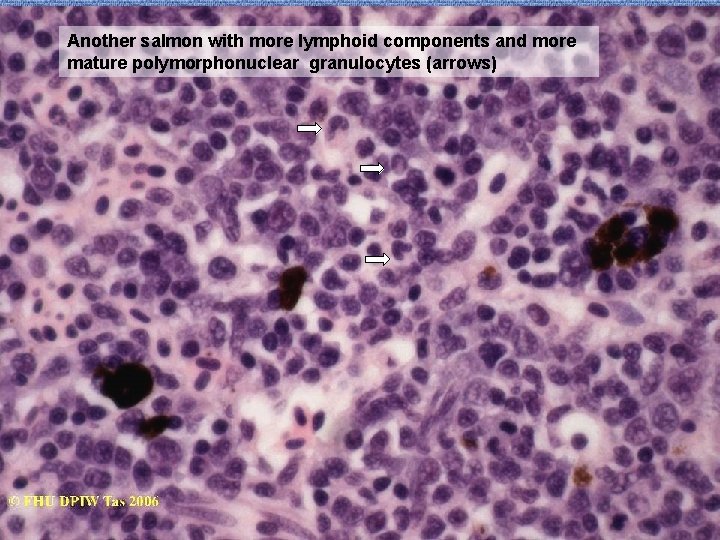
Another salmon with more lymphoid components and more mature polymorphonuclear granulocytes (arrows)

Systematic Fish Pathology Part 2 Kidney I Interstitial




















- Slides: 20

Systematic Fish Pathology: Part 2. Kidney I: Interstitial Tissue Generalised Responses Prepared by Judith Handlinger Fish Health Unit, Animal Health Laboratory, Department of Primary Industries & Water, Tasmania for The Australian Animal Pathology Standards (AAPSP) Program

Before Entering Training Program READ ME • • This series of training modules has been prepared from a teaching slide set used for short courses on fish histopathology aimed at students with a range of prior knowledge of either pathology or fish. Slides are representative of the pathology found in Australian fish in this (Tasmanian) fish laboratory, rather than a comprehensive record of all fish diseases, or diseases of all fish. There are some examples from other laboratories, including exotic diseases. The major aim is to convey an approach to diagnosis, not to cover all fish diseases. The systematic approach is relevant, regardless of species (indeed this is just applying mammalian pathology training to fish). Nevertheless the pathology of any species can only be interpreted in comparison with the known normal. As there are more fish species than all the other vertebrates together, it is necessary to overcome the temptation to consider fish just a new “species” for study, and appreciate the diversity of fish species. That this course does not cover all Australian fish, then, is within the context of using available material to impart a general knowledge of fish pathology including general patterns of fish diseases and an introduction to types of pathogen common in fish.

Acknowledgments. • • • Most material used has largely been generated within the Tasmanian Department of Primary Industries & Environment Fish Health Unit, and represents contribution of cases and photographs from many other contributors including Jeremy Carson, David Taylor, Stephen Pyecroft, Richmond Loh, Kevin Ellard, Paul Hardy-Smith, and Barry Munday. Contributors of cases from other laboratories have been acknowledged wherever possible and specific material and photographs used with permission. Any inadvertent omissions in this regard are unintended. Material exotic to Australia includes slides distributed for general teaching purposes and slides contributed specifically for the DPIW Fish Teaching set, and are acknowledged as such.

Introduction • Please refer to Part I “Consider the Fish” for an introduction to fish anatomy, histology and immunology, and how and why these differ from terrestrial animals. • I am starting the systematic examination of fish pathology with the kidney, because this is a major site of haematopoiesis, and a major reticulo-endothelial & macrophage filtration bed. • Concentrating firstly on these interstitial elements provides a general introduction to host response cells and their reactions. The importance of this organ in generalised responses means this will also introduce most of the classes of pathogens affecting fish.

Kidney Anatomy The kidney is located in a retroperitoneal location adjacent to the dorsal margin of the abdominal cavity.

Margin of torn swim bladder Kidney Embryologically the head kidney is derived from the pronephros and consists mostly of haematopoietic tissue including lymphoid tissue. The posterior kidney (also called tail or body kidney) is derived from the mesonephros, and also contains the nephrons or tubular elements.

Micro-anatomy & histology The head kidney contains both haematopoietic tissue, and one of the major reticuloendothelial / macrophage filtration beds of the fish. The salmonids (particularly the Atlantic salmon) have been used as primary demonstration species. These are well studied, but regarded as a somewhat “primitive” teleost (bony fish) species, and major differences with “higher” species will be highlighted. The Goldfish is included as an example of the latter, together with other species. Remember these are included as representative examples, rather than as an indication of their importance. Considering the large range of fish species, familiarity with the normal of each species is essential to detect subtle changes but generalised knowledge is often all that is available.

Kidney anatomy Separate head and tail lobes are present in some fish, for example the Goldfish / carps. The separation is incomplete, with thin strands of interstitial tissue connecting the more obvious lobes.

• The haematopoietic tissue is organised round a sinusoidal system of blood vessels that are lined by phagocytes. Normal juvenile Atlantic salmon. Ovary Head Kidney Dorsal skeletal muscle

• Head kidney of a young Atlantic salmon showing sinusoid-like organisation of haematopoietic tissue. Note active haematopoietic tissue, separated by the slightly dilated Detail (another salmon) showing loose sinusoid-like organization vessels. • Note the regular pattern of heavily pigmented “melanomacrophages”, a typical end stage of fish phagocytosis. • They are not melanocytes as such but contain mixed pigments which are mostly the end product of phagocytosis of pathogens or of host cells. The pigment may include melanin, haemosiderin, ceroid and lipofuscin. Blood vessel
Detail of more mixed haematopoietic tissue, showing vascular and reticular framework, early development stages (probably red cell precursors – red arrows) & 2 melanomacrophages (white arrows). (Reminder – mature red cells are nucleated in all vertebrates except mammals. )
Another salmon with more lymphoid components and more mature polymorphonuclear granulocytes (arrows)

Head kidney with macrophages undertaking erythrophagy (the result of an ongoing toxicity, which we will come to later), & demonstrating the transition and darkening of the residual pigment through golden to black/brown.

Although melanomacrophages (MMs) show little aggregation in salmonids, which are regarded as a relatively “primitive” bony fish, and form at best a loose network round the margins of haematopoietic sinusoid groups, these cells typically actively migrate towards each other to form distinctive melanomacrophage centres (MMCs) in many fish species. Melanomacrophages and MMCs are also present in the spleen (another major filtration bed), and may be present in other tissues as an indicator of recent macrophage activity. MMCs are reported to play a significant role in antigen presentations to the lymphoid system, as well as such functions as preserving iron from effete erythrocytes for recycling.

Tail kidney of young Striped Trumpeter showing fewer but larger melanised bodies (melanomacrophage centres). This includes very dark MMCs & two paler centres (arrows). Macrophages have aggregated to form MMCs as their pigment is gradually transformed and condensed, so these represent more recent phagocytosis / tissue turnover. Individual macrophage shape is still visible in the young, but not the older MMCs

This shows the head kidney - tail kidney junction, separated by a blood vessel. Posterior Details, showing glomeruli and the related convoluted tubules in tail kidney Blood vessel Note similar HP tissue in tail kidney, organised round the nephrons Head kidney

Tail kidney near junction showing extension of haematopoietic tissue between nephrons, and a similar distribution of melanomacrophages

• Nephrons consist of a glomerulus and tubules, which are not oriented into a loop or specific pattern, but loosely convoluted near the glomerulus. • Consequently the kidney is not divided into cortex and medulla: • that was a consequence of the longer tubules needed for land animals for excreting nitrogenous products • fish excrete most nitrogenous by-products across the gills as ammonia. • the major function of the nephrons is water and bivalent ion control (and some toxin excretion). • Copious water is excreted by fish in fresh-water. Most water is resorbed by fish in marine environments. Glomerulus

In the Goldfish tail kidney MM centres are well developed, (white arrows) though the pigment is pale. (The pallor indicates residual pigments other than melanin. ) Can you identify the bright eosinophilic bodies also present? (blue arrow).

Ah-Ha - ring-in!. These are thyroid follicles. Although the thyroid gland is usually in the expected location (between the lower jaws), individual follicles in other organs, especially this kidney are not unusual & in some fish are consistently present.